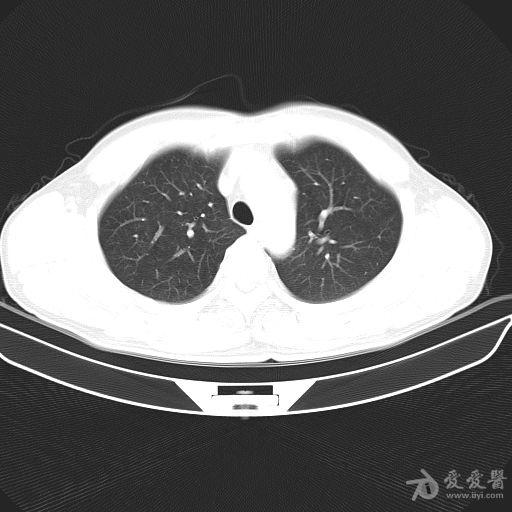

摘要:近期肺炎疫情再次引发关注,人们需要温馨有趣的故事来缓解紧张情绪。本文将讲述主人公小明的一段奇妙经历,展现他与朋友间的深厚情感纽带。这个故事将带来爱与陪伴的力量,为读者带来轻松愉快的阅读体验。
某天,小明了解到肺炎疫苗的最新进展和预防措施,他不仅想保护自己,还想向朋友们传递这些信息,让大家共同度过这个特殊时期,他开始了自己的“抗疫宣传之旅”。
小明制作了一份精美的宣传海报,上面详细介绍了肺炎疫苗的最新信息、预防措施以及保持健康的重要性,他将海报贴在社区的公告栏上,吸引了许多邻居的关注,大家纷纷停下脚步,认真阅读这份充满正能量的宣传资料。
为了以更轻松的方式普及肺炎知识,小明开始组织一系列有趣的活动,他邀请朋友们一起参加“健康运动会”,共同做运动、玩游戏,以提高身体素质和免疫力,他还组织了一个“抗疫故事会”,让大家分享自己的抗疫经历和感受,感受到爱与陪伴的力量。
在这个过程中,小明结识了许多志同道合的朋友,他们一起宣传肺炎疫苗的重要性,鼓励大家积极接种,当小明的一个朋友因害怕接种疫苗而犹豫不决时,他耐心地讲解疫苗的重要性和安全性,最终成功鼓励朋友勇敢迈出这一步。
小明发挥了自己的创造力和想象力,他制作了一些有趣的小视频和漫画,以幽默的方式普及肺炎知识,这些有趣的内容在社区迅速传播,成为大家茶余饭后的谈资和娱乐。
随着时间的推移,小明的抗疫宣传活动取得了显著的效果,越来越多的人开始关注肺炎疫苗的最新进展和预防措施,社区的团结和友爱氛围也更加浓厚,当疫情得到控制时,小明和他的朋友们一起庆祝这个胜利的时刻,更加珍惜彼此之间的友谊和陪伴。
这个故事让我们看到爱与陪伴的力量是无穷的,在这个特殊的时期,让我们珍惜彼此、携手抗击疫情,相信只要我们团结一心、共同努力,一定能够度过这个难关,迎接更美好的未来,疫情虽然带来了困难和挑战,但也让我们看到人性的光辉和社区的力量,让我们从中学到的经验和教训中汲取力量,共同为更美好的未来而努力。

还没有评论,来说两句吧...